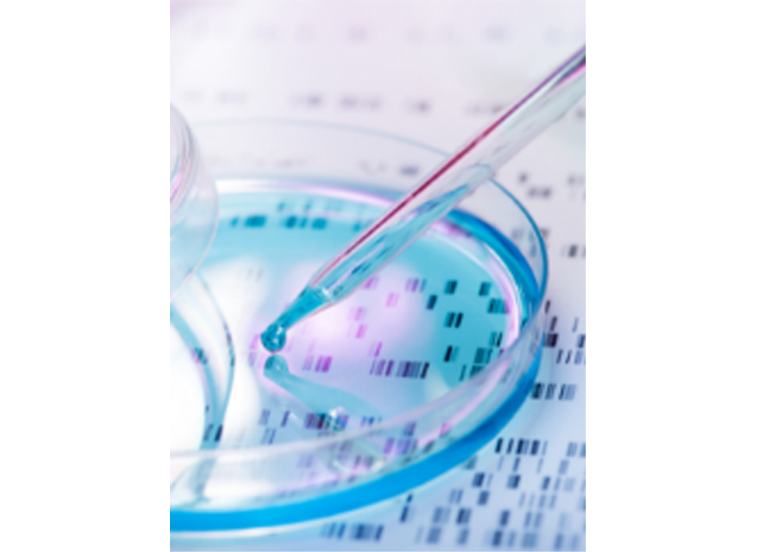

会员动态
毛发中毒品检测“手把手”第一弹——了解技术规范及相关标准
No.01.司法鉴定技术规范(SFZ)、司法行政行业标准(SFT)差别?
有标准的情况下请尽量参考标准,在没有标准的情况下可以参考技术规范。行业标准的适用性要优于技术规范。
No.02.GA/T和SF/T那个标准更适用?
GA系列标准归口公安部,SF系列标准归口司法部。鉴定资质和标准授权规范了法鉴定机对检验标准的使用范围,一般司法鉴定机构以SF系列标准的使用为主导,可同步参考GA同类标准及未来即将实施的国家标准。
No.03.毛发检测相关技术规范及行业标准分析
SF/Z JD0107016-2015《毛发中可卡因及其代谢物苯甲酰爱康宁的液相色谱-串联质谱检验方法》
SF/Z JD0107022-2018《毛发中△ 9 -四氢大麻酚、大麻二酚、大麻酚的液相色谱-串联质谱检验方法》
SF/Z JD0107025-2018《毛发中15种毒品及代谢物的液相色谱-串联质谱检验方法》
SF/Z JD0107024-2018《尿液、毛发中 S(+)-甲基苯丙胺、R(-)-甲基苯丙胺、S(+)-苯丙胺、R(-)-苯丙胺的液相色谱-串联质谱检验方法》
SF/T 0065-2020《毛发中二甲基色胺等16种色胺类新精神活性物质及其代谢物的液相色谱-串联质谱检验方法》
SF/T 0066-2020《生物检材中芬太尼等31种芬太尼类新精神活性物质及其代谢物的液相色谱-串联质谱检验方法》
SF/T 0094-2021《毛发中 5F-MDMB-PICA 等 7 种合成大麻素类 新精神活性物质的液相色谱-串联质谱检验方法》
从时间轴上分析:司法领域的相关标准发展历程是由2015年开始的。
2015年发布1项技术规范-2018年发布3项技术规范-2020年发布2项行业标准-2021年发布1项行业标准。
2020年以前基本解决了毛发中常见毒品成分鉴定的技术规范,2020年后开始拓展新精活物质的鉴定标准。
现有公安领域的GA/T的行业标准均为气质类仪器分析用的行业标准,但随着国家标准参与度的提升,公安行业也开始起草《55种毛发中滥用药物及代谢物检验液相色谱质谱法》国家标准1项,希望通过液相色谱质谱联用技术改善现有公安行业标准的落后状况。
No.04.SF系列标准的技术优势?
1.样品预处理方案更简单,省去了SPE等高耗时(SPE萃取流程繁琐)、高成本(SPE萃取柱的成本较高)的样品预处理环节;
2.采用内标物添加方案,避免交叉污染,省去公安标准要求全部化合物同步外标添加的严苛要求;
3.采用液质联用技术,实现更好的检测限,非常适用于毛发中痕量毒品及代谢物的鉴定工作。
4.SF系列技术规范和行业标准以实现各类型毒品成分的覆盖,更详尽,更实用。
No.05.如何选购液相色谱质谱仪产品呢?
1.考察液质产品的多组分同步扫描能力和仪器的稳定性
以岛津三重四极液质联用仪LCMS-8060NX为例:
*扫描速率:30000u/sec MAX
*正负离子切换速度:5msec
血浆等高蛋白类样品15000次连续进样长期稳定性好。
无惧大批量样品连续分析对分析仪器的考验。
2.考察液质联用仪对样品中杂质/噪音的去除能力
以岛津三重四极液质联用仪LCMS-8060NX为例:
LCMS-8060NX前端加载DL毛细管接口技术,中段加持三重主动信号降噪光学透镜设计,又在三重四极杆前后 增加预四极和后四极结构。有效实现基质化合物的限制进入和透镜组件(UF-Qarray II+UF-Lens II)的主动信号降噪能力,非常适用于基质复杂的毛发样品分析。
LCMS-8060NX
235种常见毒物毒品精神类药物快速检测,采用半定量分析方法的整体解决方案。
毛发经过取样、称重、清洗、研磨、溶解萃取后配合岛津完善方法包和LC/MS/MS进行多组分同时筛查分析全流程化检测。对于该方法包中的每种化合物,都可根据方法包数据快速确定含量,实现无标准品下的半定量分析。
使用LabSolutions Insight Library Screening谱库分析滥用药物,精神类药物和镇静剂在内的235种化合物快速分析方法,分析时间15分钟。
毛发样品经过粉碎,研磨,简单样品预处理即可上机分析:
本文内容非商业广告,仅供专业人士参考。